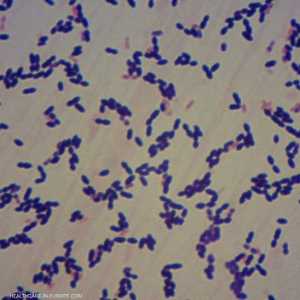
البكتيريا العقدية يمكن أن تكون قاتلة

خبراء يحذرون من "وباء قادم".. أقرب مما نتصور
10:58 - 24 مارس 2024
في مثل هذا اليوم قبل 4 سنوات بالضبط، أعلنت دول العالم عن أول إغلاق بسبب فيروس كورونا، وتم أمر السكان "بالبقاء في منازلهم".
وأصبح العمل من المنزل واقع العالم، وانفصل الأشخاص عن أحبائهم، بينما واجه العاملون في الخطوط الأمامية فيروسا جديدا وغير معروف.
ومع انتهاء أزمة كورونا الخانقة، يبقى سؤال مهم وهو، إذا ضربتنا جائحة أخرى، هل سنضطر إلى الإغلاق مرة أخرى، وكيف سيكون الأمر مختلفا؟
يحذر العلماء من أن ظاهرة الاحتباس الحراري وإزالة الغابات تزيد من احتمالية "انتقال" العامل الفيروسي أو البكتيري من الحيوانات إلى البشر والتسبب في جائحة آخر.
الوباء القادم أقرب مما نتصور
تقول الطبيبة ناتالي ماكديرموت، المحاضرة السريرية في الأمراض المعدية في جامعة كينغس كوليدج في لندن: "إننا نوجد وضعا يشجع على تفشي المرض".
وأضافت: "أعلم أن فيروس كورونا كان صعبا جدا على الناس ونريد أن نصدق أنه يمكننا العودة إلى طبيعتنا وأنا أتفهم ذلك تماما".
وتابعت: "لكن الوباء التالي أصبح قاب قوسين أو أدنى، وقد يأتي خلال عامين، وقد يأتي بعد 20 عاما، لهذا لا يجب أن نوقف حذرنا. نحن بحاجة إلى أن نبقى يقظين ومستعدين لمواجهة الوباء الجديد".
أوكرانيا على صفيح.. وتحذير من وباء قادم

وتوضح ماكديرموت أنه من خلال قطع الأشجار في منطقة الأمازون وأجزاء من أفريقيا، تقترب الحيوانات والحشرات من منازل الناس.
ومع ارتفاع درجات الحرارة، فإن تفشي الفيروسات التي ينقلها البعوض والقراد، مثل حمى الضنك، والشيكونغونيا، وحمى القرم النزفية في الكونغو، يحدث في أجزاء من أوروبا نادرا ما شوهدت من قبل.
وتقول: "مع ارتفاع درجات الحرارة في جميع أنحاء العالم، حتى بريطانيا ستصبح منطقة يمكن أن تعيش فيها تلك الأنواع من البعوض".
إلى متى ستستمر عمليات الإغلاق؟
بينما كانت هناك ثلاث عمليات إغلاق في إنجلترا، كل منها لمدة عدة أشهر، يقول البروفيسور ستيفن غريفين، عالم الفيروسات في جامعة ليدز، إنه كان ينبغي أن يكون هناك "واحدة فقط على الإطلاق".
ويقول: "كان الإغلاق بمثابة رد فعل متطرف على وضع خرج عن نطاق السيطرة بالفعل".
ولكن إذا كان هناك استثمار في وسائل التخفيف مثل تهوية الهواء في المباني العامة واللقاحات العامة والأدوية المضادة للفيروسات التي يمكن تكييفها بسرعة، فإن عمليات الإغلاق ستكون أقصر وأقل شدة، عندما يضرب الوباء القادم.
تقول ماكديرموت إنه إلى أن تعرف الحكومة والعلماء والعاملون في مجال الرعاية الصحية المزيد عن الفيروس القادم الناشئ وكيفية انتشاره، "سيكون الإغلاق أمرا لا مفر منه إلى حد ما".